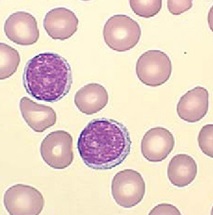

matlab:在图片中找到物体的外部边缘。
matlab:在图片中找到物体的外部边缘。
提问于 2013-12-06 21:27:40
我有一张有血迹的照片。我想做的是检测这些细胞的边缘。
我首先将这张彩色图像转换成灰度图像,然后填充这些单元格中的空洞。并利用matlab中的edge()函数进行边缘检测。因为你可以观察到某些细胞的内部部分要轻得多,所以在一个细胞内检测到了边缘。结果如下:

那么,是否有任何方法只能检测到这些细胞的外部边缘呢?
我的代码如下所示:
I = imread('film02_pattern.jpg');
t1=graythresh(I);
k1=im2bw(I,t1);
k1=~k1;
se = strel('disk',1);
k1=imfill(k1,'holes');
imshow(k1);
k1=~k1;
bw = edge(k1,'canny',[],sqrt(2));
figure,imshow(bw);回答 1
Stack Overflow用户
回答已采纳
发布于 2013-12-06 22:32:24
要处理与图像边缘相交的等高线,可以使用bwconncomp将背景与不可填充的轮廓分开。然后,而不是edge,您只能通过bwperim获得外部周长,但这只是一个变化。
I = imread('asEW3.jpg');
t1=graythresh(I);
k1=im2bw(I,t1);
k1=~k1;
se = strel('disk',1);
k0=imfill(~k1,'holes'); % new
cc = bwconncomp(k0); % new
k0(cc.PixelIdxList{1})=0; % new
k1 = imfill(k1,'holes');
cellMask = k1 | k0; % new
cellContours = bwperim(cellMask); % new
cellContours2 = edge(cellMask,'canny',[],sqrt(2)); % new
k1=~k1;
bw = edge(k1,'canny',[],sqrt(2));
figure,imshow(bw); title('original')
figure,imshow(cellContours); title('new, bwperim()')
figure,imshow(cellContours2); title('new, edge()')使用连接组件似乎有点过火,但似乎没有更容易的方法来区分背景和到达图像边缘的细胞中心,至少在imfill无法填充这些轮廓时是如此。
页面原文内容由Stack Overflow提供。腾讯云小微IT领域专用引擎提供翻译支持
原文链接:
https://stackoverflow.com/questions/20433882
复制相关文章
相似问题

